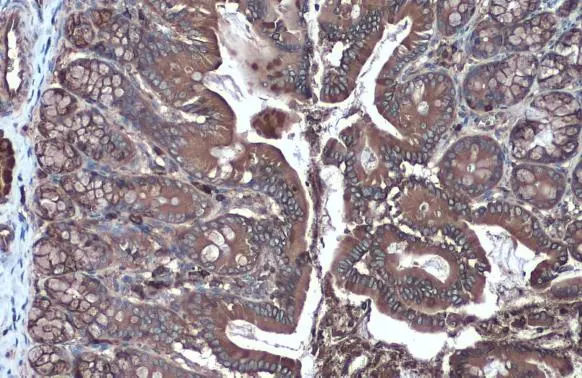
Hexokinase II antibody detects Hexokinase II protein at cytoplasm by immunohistochemical analysis. Sample: Paraffin-embedded rat colon. Hexokinase II stained by Hexokinase II antibody (GTX111525) diluted at 1:2000. Antigen Retrieval: Citrate buffer, pH 6.0, 15 min

Hexokinase II antibody detects Hexokinase II protein at cytoplasm in rat stomach by immunohistochemical analysis. Sample: Paraffin-embedded rat stomach. Hexokinase II antibody (GTX111525) diluted at 1:500.
Antigen Retrieval: Citrate buffer, pH 6.0, 15 min
Hexokinase II antibody
GTX111525
ApplicationsImmunoFluorescence, Western Blot, ImmunoCytoChemistry, ImmunoHistoChemistry, ImmunoHistoChemistry Paraffin
Product group Antibodies
ReactivityHuman, Mouse, Rat
TargetHK2
Overview
- SupplierGeneTex
- Product NameHexokinase II antibody
- Delivery Days Customer9
- Application Supplier NoteWB: 1:5000-1:20000. ICC/IF: 1:100-1:1000. IHC-P: 1:100-1:1000. *Optimal dilutions/concentrations should be determined by the researcher.Not tested in other applications.
- ApplicationsImmunoFluorescence, Western Blot, ImmunoCytoChemistry, ImmunoHistoChemistry, ImmunoHistoChemistry Paraffin
- CertificationResearch Use Only
- ClonalityPolyclonal
- Concentration0.63 mg/ml
- ConjugateUnconjugated
- Gene ID3099
- Target nameHK2
- Target descriptionhexokinase 2
- Target synonymsHKII, HXK2, hexokinase-2, hexokinase type II, hexokinase-2, muscle, hexokinase-B, muscle form hexokinase
- HostRabbit
- IsotypeIgG
- Protein IDP52789
- Protein NameHexokinase-2
- Scientific DescriptionHexokinases phosphorylate glucose to produce glucose-6-phosphate, the first step in most glucose metabolism pathways. This gene encodes hexokinase 2, the predominant form found in skeletal muscle. It localizes to the outer membrane of mitochondria. Expression of this gene is insulin-responsive, and studies in rat suggest that it is involved in the increased rate of glycolysis seen in rapidly growing cancer cells. [provided by RefSeq]
- ReactivityHuman, Mouse, Rat
- Storage Instruction-20°C or -80°C,2°C to 8°C
- UNSPSC41116161

![IHC-P analysis of esophagus cancer tissue (left) and human lung cancer (right) using GTX82791 Hexokinase II antibody [3D3].](https://www.genetex.com/upload/website/prouct_img/normal/GTX82791/GTX82791_20170912_IHC-P_w_23051501_735.webp)
![ICC/IF analysis of HepG2 cells using GTX84357 Hexokinase II antibody [4C5].](https://www.genetex.com/upload/website/prouct_img/normal/GTX84357/GTX84357_1055_ICCIF_w_23061420_212.webp)
